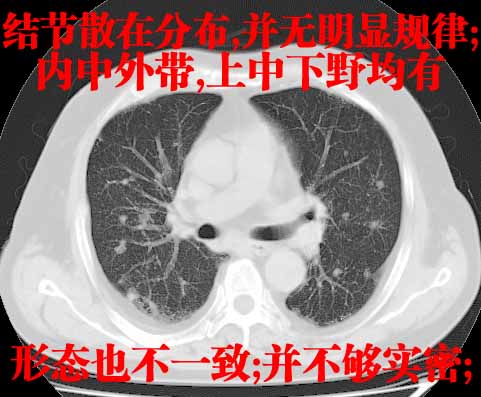

医影在线
标题: CT8348:男51岁,反复咳嗽多年,胸部多发结节影,请求会诊 [打印本页]
作者: fujin12345 时间: 2007-5-23 04:37
标题: CT8348:男51岁,反复咳嗽多年,胸部多发结节影,请求会诊
患者,男51岁,反复咳嗽多年,加重10余天,自觉精神不振,无发热,无尿频、尿急及排尿不畅,最近体重有减轻(具体不祥),化验:血常规正常,血糖正常,转氨酶不高,乳酸脱氢酶轻度增高(具体记不得了)


















[本贴已被 jiajie 于 2007-5-22 21:14:37 修改过]
作者: 余辉 时间: 2007-5-23 04:50
双肺多发结节影,以肺周围分布较多,纵隔淋巴结肿大,考虑双肺转移瘤可能性大。
另胸椎旁改变考虑神经鞘瘤可能性大
作者: jw-830 时间: 2007-5-23 04:50
双肺多发结节影及纵隔内可见肿大淋巴结考虑双肺及纵隔淋巴结转移,建议进一步检查原发灶
作者: jinning 时间: 2007-5-23 05:02
考虑双肺转移瘤,建议查原发灶
作者: 同 时间: 2007-5-23 05:05
多考虑两肺转移瘤
作者: ZHANGZHONGSHOU 时间: 2007-5-23 05:07
标题: 修改
双肺转移瘤,纵隔淋巴结转移可能性大,另外肺结核待排除,我遇到一例和此相似病例,椎间孔区都很相似,当时也诊断肺转移瘤,神经原性肿瘤,到青岛大学医学院附属医院意见相同,并且要穿刺活检,患者不同意,有亲属在结核病院,就去了,最终诊断肺结核,半年后痊愈。
[本贴已被 zhangzhongshou 于 2007-5-23 8:00:23 修改过]
作者: dyqct 时间: 2007-5-23 05:08
标题: 回复:胸部多发结节影,请求会诊
以下是引用余辉在2007-5-22 20:50:00的发言:[br]双肺多发结节影,以肺周围分布较多,纵隔淋巴结肿大,考虑双肺转移瘤可能性大。[br]另胸椎旁改变考虑神经鞘瘤可能性大
支持!!
作者: ls5092638 时间: 2007-5-23 05:14
双肺转移瘤,纵隔淋巴结/胸膜转移
作者: xulianj 时间: 2007-5-23 05:15
1双肺转移性肺癌,2t12~l1右侧椎旁神经鞘瘤。
作者: 陈永刚 时间: 2007-5-23 05:18
1.双肺散在分布小结节影 气管旁淋巴结肿大 中叶背部有胸膜增厚胸膜反应 双侧胸腔积液 考虑转移性肺癌
2. 支持胸椎旁改变考虑神经鞘瘤
作者: sunhua666 时间: 2007-5-23 05:22
双肺多发转移瘤。纵隔淋巴结肿大。胸椎右旁软组织结节,考虑神经源性肿瘤,请进一步检查。
作者: jw-830 时间: 2007-5-23 05:24
胸椎旁软组织密度影,与椎管内结构相连,相应椎间孔开大,考虑为神经源性肿瘤(神经鞘瘤)可能
作者: fujin12345 时间: 2007-5-23 05:28
谢谢各位
作者: luoyanmin 时间: 2007-5-23 05:33
肺转移瘤
作者: LWZ 时间: 2007-5-23 05:38
最好一元化解示。
作者: lihongwei 时间: 2007-5-23 05:47
以下是引用余辉在2007-5-22 20:50:00的发言:
双肺多发结节影,以肺周围分布较多,纵隔淋巴结肿大,考虑双肺转移瘤可能性大。
另胸椎旁改变考虑神经鞘瘤可能性大
作者: 国窖1573 时间: 2007-5-23 06:05
标题: 回复:ct8348:男51岁,反复咳嗽多年,胸部多发结节影,请求
以下是引用陈永刚在2007-5-22 21:18:00的发言:[br]1.双肺散在分布小结节影 气管旁淋巴结肿大 中叶背部有胸膜增厚胸膜反应 双侧胸腔积液 考虑转移性肺癌[br]2. 支持胸椎旁改变考虑神经鞘瘤[br]
作者: shenhs 时间: 2007-5-23 06:08
双肺转移瘤,纵隔淋巴结转移
作者: 心愿 时间: 2007-5-23 06:09
标题: 回复:ct8348:男51岁,反复咳嗽多年,胸部多发结节影,请求
以下是引用陈永刚在2007-5-22 21:18:00的发言:[br]1.双肺散在分布小结节影 气管旁淋巴结肿大 中叶背部有胸膜增厚胸膜反应 双侧胸腔积液 考虑转移性肺癌[br]2. 支持胸椎旁改变考虑神经鞘瘤[br]
作者: chmb 时间: 2007-5-23 06:50
1.神经纤维瘤2.双肺多发转移,
作者: 悟空 时间: 2007-5-23 06:52
首先考虑转移,非特异性感染不除外。神经鞘瘤,建议mri。
作者: jiangjing 时间: 2007-5-23 07:03
考虑 细支气管肺泡癌或转移瘤伴纵隔淋巴结肿大,神经源性肿瘤
作者: zjzjr 时间: 2007-5-23 07:08
1双肺及纵隔淋巴转移性病变,2t12~l1右侧椎旁神经鞘瘤。
作者: yangzongshan 时间: 2007-5-23 07:10
标题: 回复:ct8348:男51岁,反复咳嗽多年,胸部多发结节影,请求
以下是引用余辉在2007-5-22 20:50:00的发言:[br]双肺多发结节影,以肺周围分布较多,纵隔淋巴结肿大,考虑双肺转移瘤可能性大。[br]另胸椎旁改变考虑神经鞘瘤可能性大
作者: 流星1234 时间: 2007-5-23 07:39
标题: 回复:ct8348:男51岁,反复咳嗽多年,胸部多发结节影,请求
以下是引用余辉在2007-5-22 20:50:00的发言:[br]双肺多发结节影,以肺周围分布较多,纵隔淋巴结肿大,考虑双肺转移瘤可能性大。[br]另胸椎旁改变考虑神经鞘瘤可能性大
作者: 天南地北 时间: 2007-5-23 08:33
双肺多发结节影,以肺周围分布较多,纵隔淋巴结肿大,考虑双肺转移瘤可能性大。
另胸椎旁改变考虑神经鞘瘤可能性大
作者: whz1765 时间: 2007-5-23 09:24
双肺多发转移瘤,纵隔淋巴结肿大。胸椎右旁软组织结节,考虑神经源性肿瘤,请进mri。
作者: liuyue 时间: 2007-5-23 15:45
以下是引用余辉在2007-5-22 20:50:00的发言:
双肺多发结节影,以肺周围分布较多,纵隔淋巴结肿大,考虑双肺转移瘤可能性大。
另胸椎旁改变考虑神经鞘瘤可能性大
支持!!
作者: 小晟晟 时间: 2007-5-23 17:02
以下是引用余辉在2007-5-22 20:50:00的发言:
双肺多发结节影,以肺周围分布较多,纵隔淋巴结肿大,考虑双肺转移瘤可能性大。
另胸椎旁改变考虑神经鞘瘤可能性大
作者: luochengyi 时间: 2007-5-23 17:17
考虑双肺转移瘤,胸椎神经鞘瘤。
作者: 新页 时间: 2007-5-23 17:57
标题: 回复:ct8348:男51岁,反复咳嗽多年,胸部多发结节影,请求
以下是引用余辉在2007-5-22 20:50:00的发言:[br]双肺多发结节影,以肺周围分布较多,纵隔淋巴结肿大,考虑双肺转移瘤可能性大。[br]另胸椎旁改变考虑神经鞘瘤可能性大
作者: 还珠格格 时间: 2007-5-23 17:59
支持 1、双肺转移瘤伴纵隔淋巴结肿大 2、右侧椎旁神经鞘瘤可能性大
作者: jinguoji 时间: 2007-5-23 18:22
双肺多发转移瘤。
胸椎右旁软组织结节,考虑神经源性肿瘤。
作者: 卜一 时间: 2007-5-23 18:28
以下是引用余辉在2007-5-22 20:50:00的发言:
双肺多发结节影,以肺周围分布较多,纵隔淋巴结肿大,考虑双肺转移瘤可能性大。
另胸椎旁改变考虑神经鞘瘤可能性大
支持!!!
作者: jone-baby 时间: 2007-5-23 18:35
双肺多发结节影,以肺周围分布较多,纵隔淋巴结肿大,考虑双肺转移瘤可能性大。
另胸椎旁改变考虑神经鞘瘤可能性大
作者: 拾荒者 时间: 2007-5-24 04:18
双肺多发结节影,以肺周围分布较多,纵隔淋巴结肿大,考虑双肺转移瘤可能性大。
另胸椎旁改变考虑神经鞘瘤可能性大
支持!
作者: ysxyy 时间: 2007-5-24 04:25
标题: 回复:ct8348:男51岁,反复咳嗽多年,胸部多发结节影,请求
患者,男51岁,反复咳嗽多年,加重10余天,自觉精神不振,无发热,无尿频、尿急及排尿不畅,最近体重有减轻(具体不祥),化验:血常规正常,血糖正常,转氨酶不高,乳酸脱氢酶轻度增高(具体记不得了)



对于这类病例比较头痛,慢性病程,近期加重;多发弥漫性病变;
常见的原因:炎症;结缔组织病;肿瘤;
本例的特点:结节弥漫多发,但所有的结节都没有一个比较清楚的境界,其边界都比较模糊;
其分布并不像转移瘤那样主要分布于肺的外围,而是中心部位较外围的要多;
印象:把炎症性病变放在首位;
考虑 1、慢支并感染; 2、转移待排----右下肺那个有小泡的要小心一些;
建议正规抗炎两周后复查;如有条件请查肿瘤系列;

作者: 宝天曼 时间: 2007-5-24 06:24
1.双肺散在分布小结节影 气管旁淋巴结肿大 中叶背部有胸膜增厚胸膜反应 双侧胸腔积液 考虑转移性肺癌
2. 支持胸椎旁改变考虑神经鞘瘤
作者: zyx168 时间: 2007-5-24 08:35
1.双肺散在分布小结节影 气管旁淋巴结肿大 中叶背部有胸膜增厚胸膜反应 双侧胸腔积液 考虑转移性肺癌
2. 支持胸椎旁改变考虑神经鞘瘤
| 欢迎光临 医影在线 (http://bbs.radida.com/bbs/) |
Powered by Discuz! X3.2 |